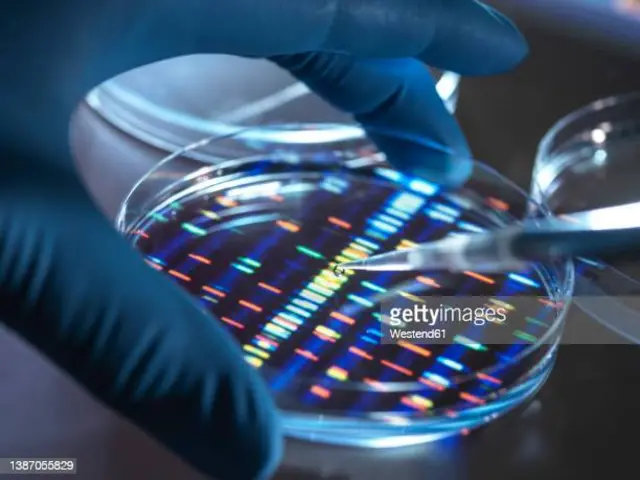
yy

Virusi vinavyosaidia kukufanya kuwa mwanadamu

Chanzo cha picha, Getty Images
Ingawa mara nyingi virusi huhusishwa na kusababisha magonjwa na wakati mwingine, milipuko yenye maafa , virusi pia vimekuwa na jukumu muhimu katika kukua kwa binadamu.
Mijusi wa Mabuya wanaoishi katika milima ya Andes ya Kolombia si kama wanyama wengine watambaao. Wakati wanyama wengi watambaao hutaga mayai yenye magamba magumu, baadhi ya spishi wanaopatikana Mubuya huzaa.
Muhimu zaidi, na cha kushangaza Zaidi Wanyama hao wana kondo la nyuma linalotumika kuwasaidai Watoto kupata chakula na hewa wakiwa tumboni kwa mama yao.
Kondo la nyuma huhusishwa zaidi na mamalia kama vile panya na binadamu ,hawa ndio viumbe wanaotambulika sana kuwa na kondo la nyuma. Lakini kwa sasa wanyama wengine nao wanagundulika kuwa na kondo la nyuma kama binadamu.
Mwaka 2001 wataalam wa wanyama Martha Patricia Ramírez-Pinilla na Adriana Jerez wa Chuo Kikuu cha Viwanda cha Santander huko Bucaramanga, Kolombia, walifichua kwamba mijusi wa Mabuya wana kondo la nyuma ambayo haina utofauti na wa binadamu.
Japo hali hii ya mnyama anayetambaa kuwa na kondo la nyuma linawashangaza wengi miaka 16 baadaye, wakati Ramírez-Pinilla aliposhirikiana na mtaalamu wa maumbile Thierry Heidmann wa Gustave Roussy huko Paris, Ufaransa na wenzake, Waligundua kwamba mijusi wana jeni ambayo ni muhimu kwa ajili ya kuundwa kwa kondo la nyuma na jeni hiyo ilitoka kwa virusi.

Chanzo cha picha, Getty Images
Virusi ambazo huingiza nyenzo zao za kijeni kwenye kiumbe alie hai hutwa virusi vinavyopunguza kinga ya mwili.
Asili yao ilieleweka kwa mara ya kwanza katika miaka ya 1960 na 1970, ingawa wengine walikuwa wametengwa miongo kadhaa kabla.
Kufuatia pendekezo la mwaka wa 1964 kwamba baadhi ya virusi vinaweza kunakili chembe zao za urithi kwenye DNA ya viumbe walio hai , watafiti waligundua DNA ya asili ya virusi katika jeni za kuku.
Pata habari za kina kutoka BBC News Swahili, moja kwa moja kupitia WhatsApp.
Bonyeza hapa kujiunga
Mwisho wa Whatsapp
Licha ya kuwa kundi kubwa na tofauti la virusi, ni virusi vinne tu vinavyopunguza kinga ya mwili ambavyo kwa sasa vinajulikana kusmbaa kwa wanadamu. Zote ziligunduliwa katika miaka ya 1980: virusi vya T-lymphotropic 1 (HTLV-1), ambayo husababisha aina ya saratani, pamoja na HTLV-2 inayohusiana kwa karibu; na virusi vya Ukimwi (VVU) vya aina 1 na 2, vinavyosababisha Ukimwi.
Ikiwa virusi vya hivi vitaambukiza seli kwenye mapafu au ngozi ya mtu, hiyo inaweza kuwa habari mbaya kwa mtu huyo, lakini ina madhara machache kwa mabadiliko ya spishi zetu kwani DNA hii haipitishwi kwa kizazi kijacho.
Hata hivyo, wakati mwingine virusi vinavyopunguza kinga mwili seli inayosaidia kuzalisha yai kwa mwananmke na mbegu za kiume kwa mwanaume (germline) ambapo DNA ya virusi inaweza kupitishwa kwa watoto wetu. Vipande hivi vya DNA ya virusi huitwa virusi vya endogenous.
Ni vipande hivi vya kurithi vya DNA ya virusi vinavyoweza kubadilisha mwendo wa mageuzi.
Virusi vya Endogenous vipo kila mahali.
Virusi ni rahisi sana hivi kwamba wanabiolojia wengi hawazingatii kuwa hai kabisa. Kila virusi kimsingi ni kifurushi cha hadubini cha nyenzo za urithi. Wanaweza kuzaliana tu kwa kuambukiza chembe hai: huharibu mitambo ya seli kutengeneza nakala zao. Kwa kufanya hivyo mara nyingi huwafanya wenyeji wao kuwa wagonjwa.
Chanzo cha picha, Getty Images
Virusi ambazo huingiza nyenzo zao za kijeni kwenye jenomu ya mwenyeji huitwa retroviruses.
Asili yao ilieleweka kwa mara ya kwanza katika miaka ya 1960 na 1970, ingawa wengine walikuwa wametengwa miongo kadhaa kabla.
Kufuatia pendekezo la mwaka wa 1964 kwamba baadhi ya virusi vinaweza kunakili chembe zao za urithi kwenye DNA ya wenyeji wao, watafiti waligundua DNA ya asili ya virusi katika jeni za kuku.
Kiwango kikubwa cha ERV za binadamu kilifichuliwa wakati rasimu ya kwanza ya jeni ya binadamu ilipochapishwa mwaka 2001.
"Ilibainika kuwa kulikuwa na idadi kubwa ya mlolongo wa virusi," anasema Heidmann. Takriban asilimia 8 ya jeni ya binadamu ina ERVs.
Baadhi yao ni ya zamani kweli. Utafiti mmoja wa mwaka 2013 uligundua ERV kwenye kromosomu 17 ya binadamu ambayo ina angalau miaka milioni 104 na labda zaidi.
Hiyo inamaanisha kuwa ni matokeo ya virusi kumwambukiza mamalia katika enzi ambayo dinosauri walitawala Dunia.
ERV hupatikana tu kwa mamalia walio na kondo la nyuma , kwa hivyo inaweza kuunganishwa punde tu baada ya kondo la nyuma kutoka kwa binamu .
ERVs hazitumiki kwa mamalia na wanyama watambaao pekee. "Wanyama wote wenye uti wa mgongo wana virusi vya endogenous retroviruses," anasema mtaalamu wa virusi vya molekuli Nicole Grandi katika Chuo Kikuu cha Cagliari nchini Italia.
ERV nyingi za binadamu si za kipekee kwa spishi zetu lakini zinaweza pia kupatikana katika angalau baadhi ya sokwe wengine, kama vile sokwe. Hii inamaanisha waliingia kwenye jeni za nyani mamilioni ya miaka iliyopita, muda mrefu kabla ya spishi zetu wenyewe kubadilika, na kisha tukazirithi kutoka kwa babu zetu.

Chanzo cha picha, Getty Images
Baadhi ya ERV husaidia mfumo wa kinga kulenga seli za saratani
Cha ajabu, hakuna ushahidi wa ERV mpya kuingia katika jeni ya binadamu katika miaka kadhaa iliyopita.
Virusi vinavyoathiri kinga mwili pekee ambazo spishi zetu zinapaswa kushughulika nazo kwa sasa ni HTLV na VVU, anasema Grandi, na hakuna hata mmoja ambaye ameripotiwa kuambukiza seli za viini. "Kwa sasa hatuwezi kuona virusi vya EVR hai kwa wanadamu," anasema Grandi.
Hii ni tofauti kabisa na spishi zingine. Dubu aina ya Koala kwa sasa wanavamiwa na koala), DNA ambayo hupatikana katika idadi fulani ya Dubu hawa lakini sio sawa na Dubu wengine.
Hivyo maambukizi yao huwa ya hali ya juu.
Asili ya kiinitete

Chanzo cha picha, Getty Images
ERV za binadamu awali zilifikiriwa kama "mifuatano ya kisukuku" isiyofanya kazi au sehemu ya "DNA. Hata hivyo, pamoja na DNA nyingi zinazodhaniwa kuwa iliachwa, inageuka kuwa ERV nyingi za binadamu zinafanya kazi.
ERV zilizochunguzwa zaidi katika jeni ya binadamu huitwa HERV-W, iliyoelezwa kwa mara ya kwanza mwaka wa 1999.
Wao husimba protini zinazoitwa seli mbili zilizounganishwa (syncytins), ambazo zinapatikana kwenye kitovu.
Kama ilivyo kwa mijusi ya Mabuya, jeni hizi za virusi ni muhimu kwa kondo la nyuma kutengenezwa.
Kiungo hiki kati ya virusi na kondo la nyuma kinaleta maana unapozingatia kile ambacho muunganiko wa seli hufanya hasa. Protini hizi zina uwezo wa kuunganisha seli mbili au zaidi katika moja.
Zilipokuwa protini za virusi, zilitumiwa na virusi kuunganisha seli na hivyo kuiambukiza. Uwezo huu wa muunganisho umechaguliwa na kondo la nyuma. Kwa kuunganisha seli kutoka kwa mama na seli kutoka kwa kiinitete, inaweza kuhamisha virutubishi hadi kwa kiinitete na kutoa taka.
Na sio wanadamu tu. Protini zinazofanana za seli mbili zilizounganishwa zinapatikana katika nyani wengine kama sokwe.
Uchunguzi wa hivi karibuni zaidi umeonyesha kuwa virusi vinavyomaliza kinga mwili vimeambukiza mamalia mara kwa mara katika historia yao ya mabadiliko, kwa hivyo vikundi tofauti vya mamalia mara nyingi huwa na syncytin tofauti zinazotokana na virusi tofauti vya retrovirus.
"Tunakisia kwamba kwa kweli kulikuwa na mwanzilishi wa kukamata ERV miaka milioni 150 iliyopita, ambayo ilisababisha kuibuka kwa mamalia walio na kondo la nyuma," anasema Heidmann.
Tangu wakati huo, maambukizo ya mara kwa mara yanaonekana kuwa yamefuta ERV ya asili, kwa hivyo haiwezi kupatikana kwa mamalia hai.
Utafiti wa mjusi wa Mabuya ulikuwa muhimu kwa sababu ulionyesha kuwa mijusi walipata kondo la nyuma tu baada ya kupata ERV kutoka kwa virusi ikipendekeza jambo lile lile lilifanyika kwa babu wa mamalia wote wenye kondo la nyuma. "Ilitoa onyesho la uhusiano kati ya kupatikana kwa kondo la nyuma na kupata syncytin," anasema Heidmann.

Chanzo cha picha, Getty Images
Historia ya seli mbili zilizounganishw na kiinitete ni mojawapo ya mifano ya kushangaza zaidi ya DNA ya virusi inayoathiri mabadiliko. Inastahiki hasa kwa sababu jeni kamili ya virusi imesalia katika jeni ya binadamu na hudhibiti protini. ERV nyingine nyingi hazisimba protini, lakini bado zina kazi.
Baadhi huchukua jukumu katika seli shina: seli nyingi zinazopatikana katika kukuza kiinitete. Baadhi ya seli shina ni pluripotent, kumaanisha kwamba wanaweza kukua katika aina yoyote ya seli katika mwili, kutoka niuroni hadi nyuzi misuli.
Familia ya retroviruses inayoitwa HERV-H ni muhimu kwa wingi. Hata hivyo, hawana kanuni za protini.
Badala yake, mfuatano wa HERV-H unakiliwa kwenye molekuli zinazoitwa RNAs, na hizi huweka seli kuwa nyingi. "Ikiwa zitakandamizwa, basi mofolojia ya seli hubadilika na inapoteza uwezo wa kudumisha hali yake," anasema mtaalamu wa virusi Christine Kozak wa Taasisi ya Kitaifa ya Ugonjwa wa Mzio na Magonjwa ya Kuambukiza huko Bethesda, Maryland.
ERV zingine hudhibiti shughuli za jeni, na kwa hivyo kudhibiti michakato ya mwili.
Kwa mfano, miili yetu hutumia kimeng'enya kiitwacho amylase kuvunja kabohaidreti kama vile wanga katika chakula chetu. "Tuna amylase kwenye kongosho na tuna amylase mdomoni kwenye mate," anasema Grandi. Jeni la amylase huwashwa kwenye tezi ya mate na DNA unaoitwa kikuzaji - ambacho hutoka kwa ERV.
Virusi vinavyotufanya tuwe na afya njema
Haishangazi, kwa kuzingatia kwamba ERV hutoka kwa virusi, wanasayansi wengi wanavutiwa na jukumu lao katika afya na magonjwa.
Mfano mmoja kama huo ulielezewa mwaka 2022 na watafiti wakiongozwa na Cédric Feschotte, mwanabiolojia wa molekuli na mtaalamu wa maumbile katika Chuo Kikuu cha Cornell huko Ithaca, New York.
Wanasayansi hao walikua wakijaribu kutafuta mfano kwa binadamu wa jambo ambalo tayari linajulikana vyema katika wanyama wengine wakati mwingine, kanuni za jeni za ERV za protini ambazo zinaweza kuchaguliwa kwa ushirikiano na mfumo wa kinga na kutumika kupigana na virusi vingine.
Virusi vinavyolengwa vinaweza kuwa na uhusiano wa karibu na virusi vilivyosababisha ERV hapo kwanza, au kuhusiana tu kwa mbali.
Feschotte anasema protini za kuzuia virusi kutoka kwa ERV zimechunguzwa katika panya, kuku na paka. "Lakini kwa ufahamu wangu hakukuwa na mifano ya hilo katika jenomu la binadamu," anasema.
Wanasayansi hao walichanganua ERV zinazojulikana katika jeni ya binadamu na kubaini mamia ya mfuatano ambao unaweza kudhibiti protini za kuzuia virusi. Kisha wakaingia kwenye jeni moja inayoitwa Suppressyn, ambayo hudhibiti protini sawa na zile zinazounda kinga ya nje ya virusi. Protini ya Suppressyn huzuia virusi vya vinavyoathiri kinga mwili kuingia kwenye seli, kwa sababu hufungamana na vipokezi kwenye membrane ya nje ya seli ambayo virusi wenyewe wangetumia kuingia kwenye seli. Feschotte analinganisha na kuingiza ufunguo uliovunjika kwenye kufuli, kuzuia mtu yeyote asifungue mlango.
Suppressyn hupatikana zaidi kwenye a kiinitete kinachokua. Hii inaashiria matumizi yake ya awali ilikuwa kuzuia virusi vinavyoathiri kinga mwili kutoka kwa viinitete, ambavyo vina kinga dhaifu sana. "Inalinda vijidudu badala ya kiumbe kwa ujumla," anasema Feschotte.
Lakini anaamini kwamba ERVs pengine hufanya mengi zaidi katika mfumo wetu wa kinga. “Tuna watahiniwa 1,500,” anasema. "Hiyo ni wingi ya jeni." Ingawa wataalamu wengi wa jenetiki bado wanafikiria ERV kama kasoro, hiyo inapotosha. "Zinaoza lakini bado zinatengeneza RNA na bado zinatengeneza protini nyingi," Feschotte anasema. "Tunahitaji kuliangalia hilo vizuri."
Na picha bado inajitokeza - utafiti uliochapishwa Aprili 2023 uligundua kuwa baadhi ya ERV husaidia mfumo wa kinga kulenga seli za saratani.
Je, ERVs hutufanya tuwe wagonjwa?

Chanzo cha picha, Getty Images
Lakini ingawa zinaweza kutulinda dhidi ya magonjwa, haitakuwa jambo la kushangaza ikiwa baadhi ya ERVs zinaweza pia kuwa na jukumu la kutoa athari mbaya za kiafya kwa wanadamu pia. "Kwa kweli kuna maslahi mengi hivi sasa katika uwezekano kwamba ERV za binadamu zinaweza kuhusishwa na ugonjwa," anasema Kozak.
Karibu asilimi 8 ya jeni ya mwanadamu hutoka kwa virusi
Kwa Feschotte, ni muhimu kufikiria ni nini hasa ERVs wanafanya - na hatujaiweka sawa kila wakati. "Tangu virusi vya endogenous retroviruses viligunduliwa, watu walikuwa wakijaribu kuviunganisha na saratani," anasema.
Hiyo ni kwa sababu zile za kwanza zilizogunduliwa kwa wanyama zilisababisha saratani. Wafadhili "walitoa fedha nyingi ili kufanya utafiti wa virusi " lakini asilimia kubwa ya watafiti hao hawakufanikiwa .
Jambo kuu ni kwamba ERV za binadamu hazina uwezo wa kutengeneza virusi, ambavyo vinaweza kuambukiza seli zingine. "Katika panya kuna mengi, na katika kuku kuna mengi," anasema Feschotte. "Wanasababisha kila aina ya ugonjwa."
Lakini ERV za binadamu zimeletwa chini ya kiwango kikubwa cha udhibiti na sehemu nyingine ya jeni, kwa hivyo usisababishe maambukizo ya virusi.
Kwa sababu ERVs zimesambazwa sana katika jeni ya binadamu, zinaweza kuratibu shughuli za jeni nyingi ambazo hutenganishwa na upana mkubwa wa mfuatano.
Michakato mingi ya mwili inahitaji jeni kuwashwa na kuzimwa katika mfuatano sahihi, na ERVs huchukua jukumu kubwa katika kudhibiti hilo. "Sasa tunapitia upya jukumu la vitu hivi katika magonjwa, lakini kupitia njia tofauti."
Jukumu la ERVs katika magonjwa limegubikwa kwa sasa. Lakini kilicho wazi ni kwamba virusi hivyo husabbisha mabadiliko mwilini.
Kwa kuingiza vipande vipya vya DNA katika jeni zetu zote, virusi vimechochea mabadiliko makubwa katika muundo wetu wa kijeni. ERVs zikiwekwa, zinaweza kusababisha kurudiwa au kufutwa kwa DNA - na ikiwa mabadiliko ni ya manufaa, yanaenea.
Jambo la mwisho ni kwamba wanadamu Wengi wana baadhi ya DNA, karibu asilimia mbili kutoka Neanderthals huku Baadhi ya watu pia wana DNA kutoka kwa kundi lingine la hominin lililotoweka, Denisovans. Na sisi sote tunapata karibu asilimia nane ya jeni zetu kutoka kwa virusi.
"Ikiwa unafikiria juu ya orodha ya jeni la mwanadamu, ni aina ya swali linalowezekana," anasema Feschotte. Takriban jeni 20,000 za hudhibiti protini zinajulikana, na idadi inayolingana ya DNA yetu hutoka kwa virusi. "Ni aina ya akili kupiga."















